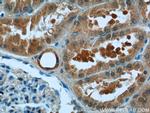
ATG2A Antibody in Immunohistochemistry (Paraffin) (IHC (P))
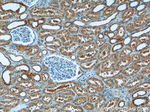
ATG2A Antibody in Immunohistochemistry (Paraffin) (IHC (P))

Search
Proteintech
ATG2A Polyclonal Antibody
{{$productOrderCtrl.translations['antibody.pdp.commerceCard.promotion.promotions']}}
{{$productOrderCtrl.translations['antibody.pdp.commerceCard.promotion.viewpromo']}}
{{$productOrderCtrl.translations['antibody.pdp.commerceCard.promotion.promocode']}}: {{promo.promoCode}} {{promo.promoTitle}} {{promo.promoDescription}}. {{$productOrderCtrl.translations['antibody.pdp.commerceCard.promotion.learnmore']}}
产品信息
23226-1-AP
种属反应
宿主/亚型
分类
类型
抗原
偶联物
形式
浓度
规格
纯化类型
保存液
内含物
保存条件
运输条件
产品详细信息
Immunogen sequence: RVQRLEYCD EAVRDPSQAP PVDVHQPPAF LHKLLQLAGV RLHYEELPAQ EEPPEPPLQI GSCSGYMELM VKLKQNEAFP GPKLEVAGQL GSLHLLLTPR QLQQLQELLS AVSLTDHEGL ADKLNKSRPL GAEDLWLIEQ DLNQQLQAGA VAEPLSPDPL TNPLLNLDNT DLFFSMAGLT SSVASALSEL SLSDVDLASS VRSDMASRRL SAQAHPAGKM APNPLLDTMR PDSLLKMTLG GVTLTLLQTS APSSGPPDLA THFFTEFDAT KDGPFGSRDF HHLRPRFQRA CPCSHVRLTG TAVQLSWELR TGSRGRRTTS MEVHFGQLEV LECLWPRGTS EPEYTEI (194-539 aa encoded by BC110650 )
靶标信息
Involved in autophagosome assembly, regulating the size of nascent autophagosomes (PubMed:28561066). Also regulates lipid droplets morphology and distribution within the cell (PubMed:22219374, PubMed:28561066). [UniProt]
仅用于科研。不用于诊断过程。未经明确授权不得转售。
生物信息学
蛋白别名: ATG2 autophagy related 2 homolog A; Autophagy-related protein 2 homolog A; bridge-like lipid transfer protein family member 4A; KIAA0404; unnamed protein product
基因别名: ATG2A; BLTP4A; KIAA0404
UniProt ID: (Human) Q2TAZ0
Entrez Gene ID: (Human) 23130